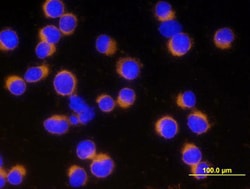

Learn More
Human/Mouse Active Caspase-3 Antibody, R&D Systems™




Description
This product(s) resides on a Fisher Scientific GSA or VA contract. If you are viewing this page as a nonregistered user, the price(s) displayed is List Price. To view your GSA or VA contract pricing, log in using your account number, or become a registered user by contacting one of our Customer Service teams. You can also view your contract price by searching for this item(s) on GSA Advantage. To place an order, contact Fisher Scientific Customer Service.
Specifications
Specifications
| Antigen | Caspase-3 |
| Applications | Immunohistochemistry, Immunocytochemistry |
| Classification | Polyclonal |
| Concentration | LYOPH |
| Conjugate | Unconjugated |
| Dilution | Immunohistochemistry 1-15 ug/mL, Immunocytochemistry 5-15 ug/mL |
| Formulation | Lyophilized from a 0.2 μm filtered solution in PBS with Trehalose. *Small pack size (SP) is supplied as a 0.2 μm filtered solution in PBS. with No Preservative |
| Gene Accession No. | P42574 |
| Gene Alias | Apopain, apoptosis-related cysteine protease, CASP3, CASP-3, caspase 3, apoptosis-related cysteine peptidase, caspase-3, Caspase3, CPP32, CPP-32, CPP32B, CPP32SREBP cleavage activity 1, Cysteine protease CPP32, EC 3.4.22, EC 3.4.22.56, LICE-1, PARP cleavage protease, procaspase3, Protein Yama, SCA-1, Yama |
| Gene Symbols | CASP3 |
| Show More |
For Research Use Only
By clicking Submit, you acknowledge that you may be contacted by Fisher Scientific in regards to the feedback you have provided in this form. We will not share your information for any other purposes. All contact information provided shall also be maintained in accordance with our Privacy Policy.